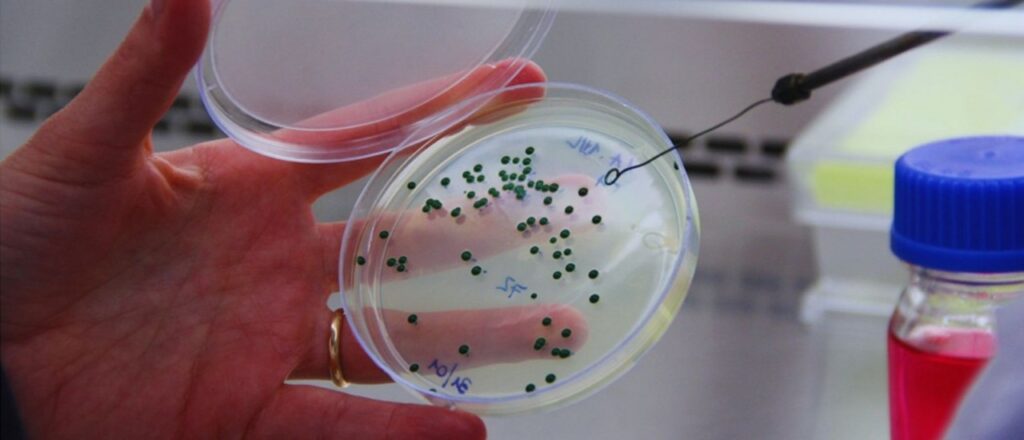

A ritmo sostenido, aumenta a nivel global la comercialización -a cargo de la multinacional Lallemand- de la cepa argentina de la levadura Saccharomyces cerevisiae, que hace 8 años el Instituto Nacional de Tecnología Agropecuaria (INTA) desarrolló en principio para darle la máxima autenticidad al vino varietal malbec, y que hoy se exporta a 14 países también para elaborar otros varietales.

Seleccionada en los viñedos mendocinos del Instituto Nacional de Tecnología Agropecuaria (INTA) en La Consulta (San Carlos, Valle de Uco, Mendoza), la levadura enológica bautizada hace casi una década como «Tango» se consolidó como una herramienta clave para realzar el carácter del vino varietal malbec y también de otros varietales típicos de Argentina. Hoy, de la mano de la empresa comercializadora multinacional Lallemand Oenology, se exporta a 14 países, entre ellos Estados Unidos, Francia, Italia y Alemania. A su vez, los científicos del INTA avanzan en la selección de levaduras autóctonas para variedades como bonarda o las criollas, que amplíen la elaboración de vinos con identidad propia y expresión territorial.
En cinco años, las exportaciones de la levadura Lalvin Tango, se duplicaron: pasaron de 833 kilos en 2018 a 1.935 kilos en 2023. Y siguen creciendo a un ritmo sostenido. Esta cepa argentina de Saccharomyces cerevisiae, seleccionada en los viñedos mendocinos del INTA La Consulta, se consolidó como una herramienta clave para realzar el carácter del malbec y otros varietales nacionales.
“Cuando se definió que el malbec era nuestro vino emblema, nos dimos cuenta de que las levaduras que usábamos eran importadas”, explicó Mariana Combina, investigadora del INTA y del Consejo Nacional de Investigaciones Científicas y Tecnológicas (Conicet) y responsable del Laboratorio de Microbiología Enológica del INTA Mendoza.
Al ser importadas las levaduras, eso hacía que perdiéramos características únicas del malbec argentino. Entonces seleccionamos una levadura propia que potenciara los aromas de frutos rojos, mantuviera la acidez y aportara untuosidad en boca.”
MARIANA COMBINA, investigadora del INTA y del Conicet


Así nació Tango, una levadura que sintetiza la esencia del vino argentino. “El aroma del vino tiene tres componentes: el primario, que viene de la uva; el secundario, que lo aporta la levadura; y el terciario, que se desarrolla durante la crianza”, detalló Combina. “Tango fue diseñada para que el malbec conserve su carácter distintivo, tanto en aroma como en sabor.”
El proceso de desarrollo demandó años de trabajo y ensayos en bodega. La cepa seleccionada mostró excelentes propiedades fermentativas, reforzando las notas frutales y el equilibrio en boca. “Seleccionamos esta levadura de unos viñedos en La Consulta y la transferimos a una empresa multinacional que la produce y comercializa”, señaló la investigadora. “Nos enorgullece -agregó- que se use en tantos países. Pero también soñamos con que exista una industria nacional que la produzca, para agregar valor en origen y beneficiar directamente a los productores locales.”
El inicio de nuevos desafíos
El éxito de Tango marcó el camino para un nuevo desafío: avanzar en la selección de levaduras nativas y autóctonas que conviven naturalmente sobre las plantas de vid en distintas regiones del país. Estas cepas, únicas en cada territorio, son el punto de partida para elaborar vinos con identidad propia y expresión territorial.
“Cada levadura tiene una huella que se traduce en el perfil sensorial del vino –explicó Combina-; por eso trabajamos en la selección de levaduras específicas para variedades como Bonarda o las criollas, que reflejan la diversidad y la historia de nuestra vitivinicultura”.
En este sentido, el INTA lleva más de una década impulsando la recuperación y valoración de las variedades criollas -como Torrontés Riojano, Criolla Grande, Cereza o Moscatel Rosado- y la selección de levaduras autóctonas asociadas a ellas. En la bodega experimental del Instituto se elaboran vinos piloto que demuestran el potencial de estos microorganismos para definir estilos y aromas propios.
“Estamos trabajando con consorcios de levaduras Saccharomyces y no Saccharomyces, lo que permite reproducir la diversidad microbiana del viñedo y obtener vinos más complejos y expresivos”, detalló Combina. “Cada selección representa una oportunidad para reforzar el vínculo entre la cepa, la región y la identidad del vino argentino”, estimó.


Todos los microorganismos aislados se conservan en la Colección de Microorganismos de INTA Mendoza (Comim), registrada oficialmente y bajo los protocolos internacionales de resguardo y uso responsable de los recursos genéticos. Este banco microbiano no sólo protege el patrimonio biotecnológico local, sino que también posiciona a la Argentina como referente en investigación enológica aplicada.
“Desde el INTA impulsamos un modelo de innovación que nace en el territorio y vuelve a él en forma de valor; cada levadura que seleccionamos cuenta una historia: la del suelo, el clima, la planta y la gente que trabaja en el viñedo; esa combinación es lo que hace que nuestros vinos sean únicos y reconocidos en el mundo.”, concluyó Combina.
Con la levadura Tango abriendo mercados y nuevos desarrollos en marcha, el INTA reafirma su rol protagónico en la construcción de una vitivinicultura argentina con carácter, identidad y calidad reconocida internacionalmente.
Fuente: Instituto Nacional de Tecnología Agropecuaria (INTA), Gobierno de Argentina